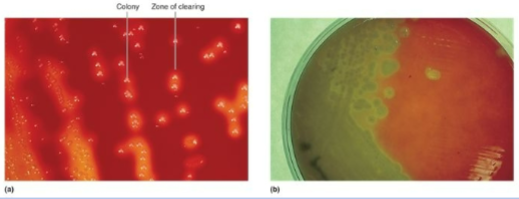
<p>Contain nutrient media and 5% sheep red blood cells</p><p>• Routine clinical use to <strong><u>grow hemolytic bacteria</u></strong></p><p>• An example of <strong><u>complex</u> </strong>and <strong><u>differential</u> </strong>media</p>
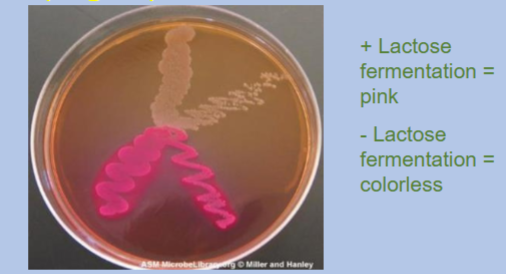
<p>Selects for <strong>gram negative bacteria</strong></p><ul><li><p>An example of <strong><u>selective</u></strong> and <strong><u>differential</u></strong> media</p><ul><li><p>Lactose makes it differential</p></li></ul></li></ul><p></p>

BIOL 251 CH 9 Study Points
1/37
There's no tags or description
Looks like no tags are added yet.
Name | Mastery | Learn | Test | Matching | Spaced | Call with Kai |
|---|
No analytics yet
Send a link to your students to track their progress
38 Terms
Pure culture
A population of microorganisms descended from a single cell
Mixed culture
More than one species growing together
Define and explain what a colony is
group of a single microorganism
single colony is a pure culture
Explain binary fission
bacterial reproduction, asexual
cell gets longer, DNA replicates
DNA moved into future daughter cell, cross wall forms
cell divides into two cells
cells separate

Describe exponential growth
growth that scales with size, bigger the population the faster it grows
usually expressed 2^n
growth curve
lag phase: no increase
log phase: exponential growth
stationary phase: plateau in living cells, rate of cell division and death equal
death/decline phase: exponential decrease
What kind of information can be derived from a growth curve?
responses to environment/stimuli
doubling time
carrying capacity
serial dilution
dilution of the original culture by multiples of 10 to obtain plates with CFUs between 30-300

Counting via hemocytometer
counts red blood cells
easy to use, relatively fast, and inexpensive
the counting chamber does not work well with dilute cultures because there may not be enough cells to count
Counting cells via Coulter Counter
counts individual cells as it passes thru the detector
rapid and accurate within a range of concentrations
however, if the culture is too concentrated, more than one cell may pass through the aperture at any given time and skew the results.
counting by measuring Turbidity
indirect cell count, uses a spectrophotometer to measure the turbidity of a sample
more turbid sample contains more microbial cells
fast method to estimate cell density as long as there are enough cells in a sample
counting using Membrane Filtration
directly count the number of microbial cells present
works if the sample is more dilute and in a larger volume
Explain what a direct plate count is and how it is done
used to calculate living bacteria in sample
serial dilution
plating sample
spread plate
pour plate
incubation
counting colonies
30-300 CFU range
CFU formula calculation
Obligate aerobes
requires oxygen
grows at the top of tube

Obligate anaerobes
grow in the absence of oxygen (intolerant of oxygen)
grows at bottom of tube

Facultative anaerobes
grow in aerobic or anaerobic conditions, thrives more in oxygen
heavy growth at the top of the tube and growth throughout the tube

Aerotolerant anaerobes
(anaerobic respiration) indifferent to the presence of oxygen
equal growth throughout

Microaerophiles
require between low atmospheric oxygen levels (5 – 15%)
grows slightly below the top

Explain how microbes tolerate ROS
enzymes break down ROS, electron donor (reduced compound) oxidizes peroxides to water
superoxide dismutase
peroxidase
catalase
What is the catalase test used for? Explain how a positive result is achieved
detects presence of catalase enzyme
positive result shown by formation of bubbles
Know about the C. perfringens example
C. perfringens is an obligate anaerobe meaning it grows that grows devoid of oxygen
dead tissue no longer supplied by oxygen makes an ideal environment for its growth
dead tissue will have to be removed (debrided)
pH and bacteria
measure of H+ ion concentration
Microbes have an optimum, minimum and max
Highly acidic or alkaline environments inhibit bacterial growth
types of bacteria:
Neutrophiles: pH range is 5–8
Acidophiles: Optimal pH is below 5.5
Alkaliphiles: Optimal pH above 8.5

pH food preservation
Lemon juice, vinegar, and pickled foods are used in preservation as highly acidic or alkaline environments inhibit bacterial growth
pH of vinegar is about 2.5 - 3.0
H. pylori example
this bacteria is able to survive the extreme acidity of the stomach despite being a neutrophile
how?
creates a microenvironment in which the pH is nearly neutral
produces large amounts of the enzyme urease, which breaks down urea to form NH4 + and CO2, ammonium ion raises the pH of the
testing?
patient given urea containing radioactively labeled carbon atoms
if H. pylori present, it will break down urea producing radioactive CO2 in patient’s breath
uses flagella to corkscrew through mucosal lining, mucus production decreases, stomach lining not protected from acidic environment
Cause of most peptic ulcers
temperature effect on microbes
the optimum temperature (highest growth rate temp.) depends on the species
practical use:
Food preservation
refrigeration prevents spoilage
freezing temps microbes unable to grow and divide
Infectious diseases
microbes able to grow at body temp, 37 C
temperature range types
psychrophile: -5 to 15 C
mesophile: 20 to 30 C
thermophile: 45 to C 70
hyperthermophile: 70 C or greater

L. monocytogenes example
Ubiquitous in environment
known to survive under various conditions of refrigeration, freezing, heating, and drying
Transmission via contaminated foods; problem for food industries
Can form biofilms on food processing equipment
foods that do not require further cooking are under great risk
Immunocompromised and pregnant are most susceptible
problematic for fetus (can cause placental barrier)
Understand solute (salt) concentration and food preservation
High salt concentrations are used to preserved foods, causes plasmolysis
Foods with high dissolved solute (salt or sugar) are naturally preserved
Jams, honey
Mustard, ketchup
Know about the S. aureus example
S. aureus can survive in high salt concentrations
Associated with improper food handling and warm storage
Causes rapid-onset gastroenteritis without bacteria in the bloodstream
Understand/explain how bacteria are cultured in the laboratory
Must know growth and nutritional requirements
Environmental requirements must be known
Broth cultures or agar plates
selective vs differential media
selective - allow some organisms to grow while inhibiting others
differential - Distinguish between organisms that all grow
Blood agar plates
Contain nutrient media and 5% sheep red blood cells
• Routine clinical use to grow hemolytic bacteria
• An example of complex and differential media
MacConkey agar plates
Selects for gram negative bacteria
An example of selective and differential media
Lactose makes it differential
nutrient agar
used for routine lab work, general purpose, supports growth of a variety of nonfastidious bacteria
not selective or differential
Mannitol Salt Agar (MSA)
Selective: high salt
Differential: mannitol fermentation
Thayer-Martin agar
Selective (antibiotics) - selects for (fastidious pathogens)
Used for Neisseria
Chocolate agar
Not selective or differential
Used for fastidious bacteria - picky organisms
Environmental needs of bacteria
Incubators
• CO2 and Non-CO2 incubators
• Stationary and shaking incubators